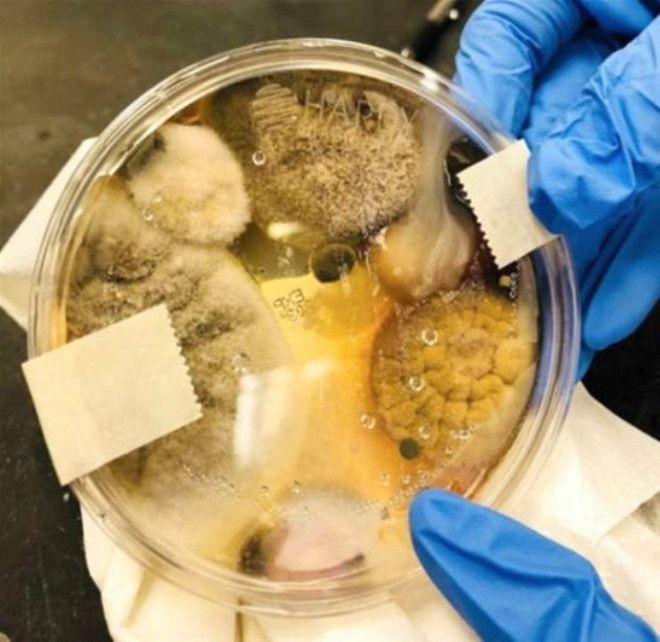
6 köklü diş dişçilerin kabusu oldu! - Sayfa 24

Baş parmağını kaybeden bir kişiye ayak baş parmağı nakli yapıldı.
6 köklü diş dişçilerin kabusu oldu!
Dünya üzerinde bizim bilmediğimiz birçok şey oluyor. Dolayısıylada her gün şaşırtıcı fotoğraflarla karşılaşıyoruz. İşte sizi şaşırtacak kareler...


Bu Sonya Leslie, gözünde bir benle birlikte doğmuş.

Uyuyan bir ayının ayak pençesi

Yıldırımdan sağ kalan bir kadının vücudu

9 bin yıl önce yaşayan kadın

Milattan önce 7000 yılında yaşamış Dawn isimli bir genç kızın 1993'te Yunanistan'da bulunan iskeleti, ölümünün 9 bin yıl ardından hayat buldu.Öldüğünde 15 ile 18 yaşları arasında olduğu saptanan Dawn'ın öne çıkık çenesinin sebebinin hayvan derilerilerini yumuşatmak için çiğnemesi olduğu belirtildi.

“Kız kardeşim alerji testini tamamladı ve test ettiği her şeye alerjisi olduğu ortaya çıktı”

Arapların deve traşı sanatından bir örnek

“Sağ başparmağımın eğilemediği bir şekilde doğdum”

Meksika'daki yangına müdahale eden Amerikan itfaiyecileri: Sınırın üstünden

Bir gölgeyi paylaşmak zorunda kalan koyunlar

Kanada'daki buzdan sütunlar

Nevada Çölü'ndeki güneş paneli tarlası Nevada Çölü'ndeki bu güneş paneli tarlasının fotoğrafı uçakla seyahat eden bir yolcu tarafından çekilmiş. Enteresan bir başka bilgi ise burada üretilen enerji, erimiş tuzun içinde depolanıyor.

Jüpiter'deki kasırga ve hortumların görüntüsü

Dişçilerin kabusu bir diş

Biri sağlıklı bir muhabbet kuşu, diğeri ise bir tüy hastalığından müzdarip

Bu kütük eski bir ekmek parçası gibi görünüyor

Osage ağaç meyvesi

Chicago'da bir kar fırtınasından sonra donmuş bir bisiklet

Benzin istasyonunda verilen garip fiş

Kaliforniya sahilinde bulunmuş simetrik deniz kestanesi

Simetrik halka gök kuşakları

Kesilmiş bir kütüğün üstünden büyüyen bir ağaç
Kurutma makinelerindeki mikropları ortaya çıkaran bir test.